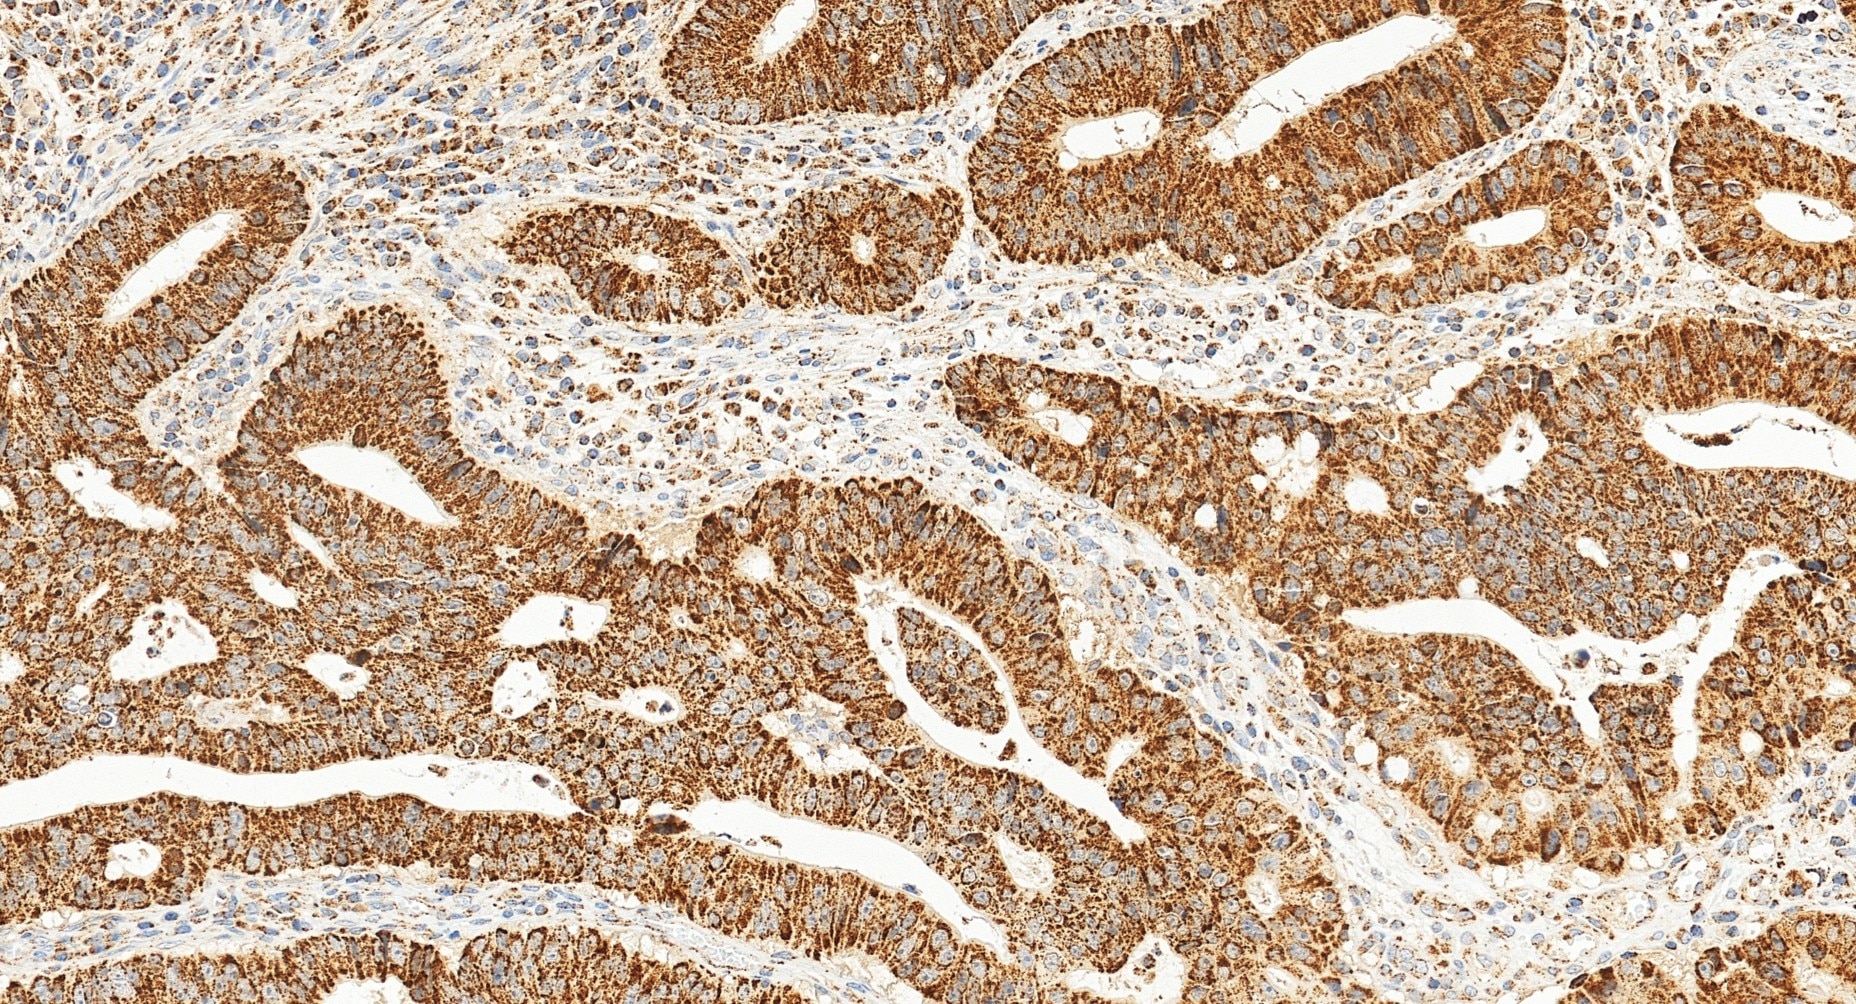
Immunohistochemical analysis of paraffin-embedded human colon cancer tissue slide using 22586-1-AP (TFAM antibody) at dilution of 1:2000 (under 20x lens). Heat mediated antigen retrieval with Tris-EDTA buffer (pH 9.0). Immunohistochemistry (IHC) staining of human colon cancer tissue using TFAM Polyclonal antibody (22586-1-AP)

Tested Applications
| Positive WB detected in | HEK-293 cells, HeLa cells, HepG2 cells, Jurkat cells, K-562 cells, MCF-7 cells |
| Positive IP detected in | HEK-293 cells |
| Positive IHC detected in | human colon cancer tissue Note: suggested antigen retrieval with TE buffer pH 9.0; (*) Alternatively, antigen retrieval may be performed with citrate buffer pH 6.0 |
| Positive IF/ICC detected in | HepG2 cells |
Recommended dilution
| Application | Dilution |
|---|---|
| Western Blot (WB) | WB : 1:5000-1:50000 |
| Immunoprecipitation (IP) | IP : 0.5-4.0 ug for 1.0-3.0 mg of total protein lysate |
| Immunohistochemistry (IHC) | IHC : 1:1000-1:4000 |
| Immunofluorescence (IF)/ICC | IF/ICC : 1:200-1:800 |
| It is recommended that this reagent should be titrated in each testing system to obtain optimal results. | |
| Sample-dependent, Check data in validation data gallery. | |
Published Applications
Product Information
22586-1-AP targets TFAM in WB, IHC, IF/ICC, IP, CoIP, chIP, ELISA applications and shows reactivity with human samples.
| Tested Reactivity | human |
| Cited Reactivity | human, chicken, zebrafish, bovine, goat |
| Host / Isotype | Rabbit / IgG |
| Class | Polyclonal |
| Type | Antibody |
| Immunogen |
CatNo: Ag18299 Product name: Recombinant human TFAM protein Source: e coli.-derived, PGEX-4T Tag: GST Domain: 1-246 aa of BC126366 Sequence: MAFLRSMWGVLSALGRSGAELCTGCGSRLRSPFSFVYLPRWFSSVLASCPKKPVSSYLRFSKEQLPIFKAQNPDAKTTELIRRIAQRWRELPDSKKKIYQDAYRAEWQVYKEEISRFKEQLTPSQIMSLEKEIMDKHLKRKAMTKKKELTLLGKPKRPRSAYNVYVAERFQEAKGDSPQEKLKTVKENWKNLSDSEKELYIQHAKEDETRYHNEMKSWEEQMIEVGRKDLLRRTIKKQRKYGAEEC Predict reactive species |
| Full Name | transcription factor A, mitochondrial |
| Calculated Molecular Weight | 246 aa, 29 kDa |
| Observed Molecular Weight | 25 kDa |
| GenBank Accession Number | BC126366 |
| Gene Symbol | TFAM |
| Gene ID (NCBI) | 7019 |
| RRID | AB_11182588 |
| Conjugate | Unconjugated |
| Form | Liquid |
| Purification Method | Antigen affinity purification |
| UNIPROT ID | Q00059 |
| Storage Buffer | PBS with 0.02% sodium azide and 50% glycerol, pH 7.3. |
| Storage Conditions | Store at -20°C. Stable for one year after shipment. Aliquoting is unnecessary for -20oC storage. 20ul sizes contain 0.1% BSA. |
Background Information
TFAM, also named as TCF6L2, MtTF1, TCF6, TCF6L1, TCF6L3 and mtTFA, is a mitochondrial transcription factor that is a key activator of mitochondrial transcription as well as a participant in mitochondrial genome replication. It is involved in mitochondrial transcription regulation. TFAM is required for accurate and efficient promoter recognition by the mitochondrial RNA polymerase. It activates transcription by binding immediately upstream of transcriptional start sites. TFAM is able to unwind and bend DNA.
Protocols
| Product Specific Protocols | |
|---|---|
| IF protocol for TFAM antibody 22586-1-AP | Download protocol |
| IHC protocol for TFAM antibody 22586-1-AP | Download protocol |
| IP protocol for TFAM antibody 22586-1-AP | Download protocol |
| WB protocol for TFAM antibody 22586-1-AP | Download protocol |
| Standard Protocols | |
|---|---|
| Click here to view our Standard Protocols |
Publications
| Species | Application | Title |
|---|---|---|
Cell Res Mitochondria-localized cGAS suppresses ferroptosis to promote cancer progression | ||
Adv Mater Neonatal Tissue-derived Extracellular Vesicle Therapy (NEXT): A Potent Strategy for Precision Regenerative Medicine | ||
Cell Metab Mitochondrial Damage and Activation of the STING Pathway Lead to Renal Inflammation and Fibrosis. | ||
Nat Cell Biol Mitochondrial RNA granules are fluid condensates positioned by membrane dynamics. |
Reviews
The reviews below have been submitted by verified Proteintech customers who received an incentive for providing their feedback.
FH Dhanwini (Verified Customer) (09-24-2025) | Good
|
FH Robert (Verified Customer) (09-24-2025) | Works as intended. Used for CE-SDS.
|
FH Sneha (Verified Customer) (09-24-2025) | GOOD
|
FH Emilie (Verified Customer) (09-24-2025) | Produced accurate detection at the expected molecular size range.
|
FH Michael (Verified Customer) (09-23-2025) | Works great!!
|
FH Henry (Verified Customer) (09-23-2025) | GOOD RESULTS
|
FH Sebastian (Verified Customer) (10-25-2023) | Good detection signals for TFAM in western blot of liver from old and young mice, some unspecific bands were slightly visible
|
FH Tanusree (Verified Customer) (12-18-2019) | Product worked well in WB at 1:500 dilution.
|